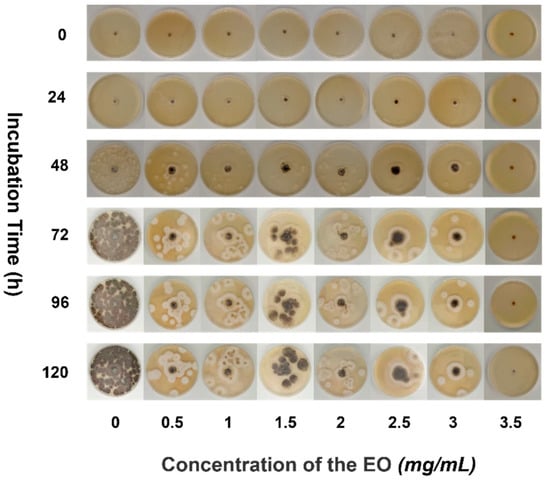

Abstract
To verify the anti-fungus properties of the crop-harmful pseudocercospora, the essential oil (EO) of pomelo peel (PP) was extracted by a single factor combined with response surface optimization. Meanwhile, the composition and activity of EO were studied. The PP was squeezed by a screw extruder and pretreatmented by pectinase, then extracted by microwave-assisted steam distillation. The optimal conditions were as follows: pectinase dosage was 69.17 μmol/g, microwave power was 651.42 W and extraction time was 43.84 min. The dry weight (DW) yield of PPEO reached 14.63 mL/kg DW after BBD optimization. There were 23 compounds in the PPEO identified by GC-MS. Limonene, α-phrenbutene, and laurene in PPEO accounted for 79.31%, 4.72%, and 3.46%, respectively. In addition, the antifungal was effective when the concentration of PPEO was 3.5 mg/mL. Therefore, this study has guiding significance for the development of natural resources.
1. Introduction
Toxins produced by fungus can contaminate crops to varying degrees [1]. Pseudocercospora fungus (PF) is a representative fungus commonly found in banana, guava, and other fruit crops [2,3] and is also a persistent pathogen that is difficult to eradicate. Synthetic chemicals used as antifungal drugs can effectively protect crops and plants. Chemical fungistatic drugs, on the other hand, frequently leave residues after treating diseased crops [4] and are highly toxic to mammals [5], which is the reason for the growing interest in developing safer methods.
Pomelo (Citrus maxima ‘Shatian Yu’) peel (PP), a byproduct of pomelo fruit juice processing, is rich in essential oil (EO) and flavonoids [6,7]. The pomelo peel essential oil (PPEO) has been shown to consist of complex mixtures of many monoterpenes, oxidized monoterpenes, and sesquiterpenes [8]. In addition, PPEO has been reported to possess broad bioactivity, such as anti-inflammatory, anxiolytic, antioxidant, and antimicrobial effects [9]. which is generally considered safe, and studies have shown that PPEO has potent antifungal and antiviral properties [10,11].
To isolate EO compounds, plants are first subjected to cell fragmentation via external mechanical forces [12], followed by the EOs slowly diffusing from the cells onto the surface of the plant material to be isolated [13], which can significantly reduce the difficulty of EO isolation. Pre-crushing the raw material before extraction can disrupt its entire structure and facilitate the separation of target analytes such as EOs [14]. However, conventional fine comminution results in particles that are too small, which is incompatible with solid-liquid separation [15]. Meanwhile, the comminution method will generate noise and dust during the pretreatment stage of processing [11]. Screw extrusion pretreatment enables adequately ruptured cell walls in plants [16] and promotes the accumulation of shear forces, which leads to cell rupture when shear stress exceeds a predetermined value, resulting in the leakage of volatile components [17]. The material inside the barrel is propelled forward by the frictional force generated between the screw and the barrel, and is constantly under pressure due to t the shrinkage of the screw space, thus improving the destruction effect [18].
The addition of catalysts can significantly improve the extraction yield of natural products from plants; enzymolysis-assisted extraction is a viable alternative to traditional extraction methods [19]. Pectinase treatment was previously demonstrated to dissolve cell wall fibers [20], thus releasing more active ingredients and helping in increasing the yield of active ingredients during extraction [21].
Microwave-mediated hydrodistillation is a new technology recently developed for extraction and separation, highly regarded performance of this technology is ascribed/owing to its time savings and lack of noise pollution [22]. It destroys the cell wall instantly and increases the permeability of the protoplasmic layer, which is used to extract inclusions [23,24]. Microwave irradiation can improve the transfer of heat energy in the materials to capillary fibers and enhance the water absorption capacity of plant materials, which can increase the extraction efficiency [25]. Radiation heating can work within a short period. Microwave irradiation can induce molecular dipole migration, which is knowed as the cause of hydrogen bond rupture in the plant cell wall [26].
As a result, we hypothesized that pretreatment of PP with pectinase would aid in increasing the extraction rate of EO. We pretreated PP using spiral extrusion, and verified the antifungal acitivity of PPEO, thereby reducing disease contamination in agricultural production and improving food quality.
2. Materials and Methods
2.1. Materials and Apparatus
Pomelos (Citrus maxima ‘Shatian Yu’) were purchased from the City Agricultural Trade Mall (Meizhou, China). The other materials were as follows: water purifier (Millipore, MA, USA); anhydrous sodium sulfate (Purity ≥ 99%) and pectinase, Tianjin Fuchen Chemical Reagent Factory (Tianjin, China); N-hexane (Chromatographic purity), Tianjin Guangfu Science and Technology Development Co., Ltd. (Tianjin, China).
The microwave extraction device is composed of three parts: microwave heating, EO collection, and condensed reflux. The maximum microwave radiation output power is 700 W, and the inner of the microwave oven cavity is 600 × 550 × 560 mm (Heyuan Analytical Instrument Co., Ltd., CW-2000, Shanghai, China). The power can be adjusted continuously as needed, the maximum power is 700 W, and an external knob controls the power.
The screw extrusion process is completed by equipment (MG-1232, Jinyimei Electric Co., Ltd., Foshan, China), which includes a motor, a screw (120 mm), and a feeding inlet (diameter is 50 mm), and a sieve plate. The material was cut by the shearing blade, and then left the screw extrusion apparatus from the extrusion hole of the sieve plate.
2.2. Pretreatment and EO Separation
The PP was diced with a knife, 50 g PP was crushed by a screw, then soaked in pectinase solutions of varying concentrations for 60 min at 50 °C (100 mL of distilled water previously was dissolved with different amounts of pectinase powder to obtain 20–100 μmol/g solutions was added into the flask). Subsequently, the pretreated PP-pectinase solutions were placed in a 1000 mL round bottom flask for extraction (After the preliminary experiment, the optimal solid-liquid ratio is 1:3). A Clevenger-type apparatus was used for the hydrodistillation process. Finally, anhydrous sodium sulfate was used to dry the EO and stored at 5 °C.
2.3. Single-Factor and Response Surface Experiments Optimization
Table 1 shows factors and levels were in the response surface, with the EO yield (Y) as the response value, X1, X2, and X3 represent different factors, and the values 1, 0, and −1 were used to represent the high, medium, and low levels, respectively (In the process of response surface optimization, the three values represent the high and low levels close to the optimal level).

Table 1.
Factor and Levels in Response Surface Analysis.
2.4. GC-MS Detection
The EO samples were subjected to gas chromatographic detection using the EO detection method, which involves diluting the EO with hexane and filtering it through a 0.45 m organic phase filter membrane. The GC-MS conditions were as follows: inlet temperature 280 °C; interface temperature 280 °C; carrier gas flow rate 1.5 mL/min; injection volume 1 ul; shunt ratio 10:1; initial temperature 50 °C, ramp up to 100 °C at a rate of 5 °C/min, and hold for 5 min. The chromatographic column was purchased from Source Leaf LTD, HP-5MS, 60 m × 250 μm × 0.25 μm (Shanghai, China).
2.5. Pseudocercospora Isolation
Isolation and culture of PF strains: the entire strain isolation procedure was completed on a sterile operation table. The decayed guava was cut and ground then added to normal saline and shaken for 30 s. After diluting the gradient to 10-8 CFU/mL, 100 μL was evenly applied to the solid medium, sealed at 28 °C for 72 h. The morphology of pseudocercospora was observed, photographed, and recorded under a microscope.
2.6. Antifungal Experiment
The AGAR dilution method was developed to identify the antifungal properties of EO. The blank control was sterile distilled water. We were fixed EO with 0.1% Tween 80, and pour the EO solution into a solid medium below 50 °C, the medium concentration range was 0–3.5 μg/mL, thoroughly mixed evenly, and injected it into the Petri dish, and allowed to cool and solidify. A hole punch was used to cultivate a 5 mm small cake from the cake and placed it in the middle of each concentration medium. Pseudocercospora growth was observed and recorded in three parallel experiments at 26 °C for 120 h at each concentration gradient. After the pseudocercospora growth reached the edges of the negative control plates with little change in coverage, the antifungal rate was calculated by Wael et al. method: [(DC−DT)/DC] × 100, where DC and DT represent the average diameters of the fungal colony for control and treatment, respectively.
3. Results and Discussion
3.1. Extraction and Optimization of EOs
3.1.1. Extraction Rate under Different Factor Levels
According to Figure 1A, the yield of pomelo peel EO pretreated with pectinase at concentrations ranging from 20–100 μmol per unit time was 4.71–6.45 mL/kg DW, while the yield of the untreated samples was 4.38 mL/kg DW. The rate of increase in EO yield decreased when pectinase was added at a concentration of 60–100 μmol, most likely because this concentration of pectinase was able to cause greater damage to the inner cell wall of the raw material, which was consistent with the reported pattern in previous studies. As a result, the optimal amount of pectinase to add was determined to be 60 μmol.

Figure 1.
The yield of essential oil effected by different factors. Figure (A–C) respectively represents the effects of pectinase addition amount, microwave time and microwave power on the yield of essential oil.
The relationship between microwave time and EO yield is depicted in Figure 1B. The yield of EO is proportional to the duration of microwave irradiation. When the microwave time is only 10 min, the yield of EO is less than 2 mL, and this ratio gradually increases with time. The microwave time of 40 min almost achieves the maximum yield of EO (8.43 mL/kg DW). The majority of the EO extraction in the raw material has been completed when the time reaches 40 min. As can be seen from Figure 1C, the yield of EO increased significantly in the microwave power range of 235–385 W, while the extraction yield of EO decreased slightly as the microwave irradiation power changed from 385 to 700 W, which is because the PP liquid has a strong ability to absorb microwave energy at the low power stage. As the power continues to increase to 700 W, which may result in scorching of the plant samples and thus the extraction yield of EO increase slightly. Therefore, the most appropriate power is conducive to maximizing EO [27]. As a result, 385–700 W was selected as the range of microwave power for subsequent experiments.
3.1.2. Extraction Kinetics
As illustrated in Figure 2, the microwave time of 0–40 min yielded EOs in the range (0–8.2 mL/kg DW), which may be since the method of microwave extraction can rapidly reach a higher temperature. After the cell expands, ruptures and the EO flows out, the thermal molecules accelerate their movement. However, when the extraction lasted 40–50 min, there was less variation in yield. Excessive extraction time reduces the stability and yield of the extraction, and a significant amount of EOs present in the raw material gradually disappears. Meanwhile, as shown in Figure 2, the yield of EO increased slightly as the microwave power increased from 540 to 700 W, and the kinetic extraction curve objectively demonstrates the yield of EO per unit of time under various power conditions. After careful consideration, it was determined that the optimal microwave time was 40 min, and the optimal extraction power was 540 W, which produced the same results as the extraction of nutmeg EO using microwave-assisted distillation by Mathew et al. [28].

Figure 2.
Extraction kinetics on yield of essential oil.
3.1.3. Response Surface Optimization
Response surface method was used to optimize the single-factor results [23], and the fitting effect was discussed by 3D graph.
As is shown in Figure 3a, the dosage of pectinase had the most significant impact on EO yield. When the 70 μmol/g pectinases were added, the yield approached 13.40 mL/kg DW, tending to be maximized. However, when the dosage of pectinase continued to increase, EO yield leveled off. As shown in Figure 3b, with the increase in microwave time and pectinase content, the EO yield gradually increased to 13 mL/kg DW. The material was fully heated with the increase of microwave time; when the time reaches about 40 min, prolonging extraction time is not conducive to the extraction of essential oil. In Figure 3c, the yield of EO increased with the increase of microwave time and power and leveled off when microwave time reached 40 min and 540 W. Meanwhile, excessive power and time will lead to more consumption, in order to further obtain the optimal factor level, the quadratic polynomial regression model formula for each factor to the response value was obtained:
Y = 13.65 + 2.18X1 + 0.63X2 + 0.71X3 + 0.11X1X2 + 0.033X1X3 + 0.53X2X3 − 2.49X12 − 0.78X22 − 0.71X32


Figure 3.
Response surface figure of the yield of PPEO influenced by different factors ((a–c): represents the influence of different factors on the yield of essential oil, (a): microwave power and pectinase addition amount; (b): microwave time and pectinase dosage; (c): Microwave time and microwave power).
Table 2 shows the ANOVA results of the regression equation describing the yield of EO (Y), with a model p-value of 0.0001, indicating a highly significant regression model. The lack of fit term was not significant (p = 0.1193 > 0.05), indicating that the unknown factors had little effect on the experimental results and that the test error can be ignored; the model has an R2 of 0.9912 and a CV% of 2.843%, indicating a high degree of model fitting. The results demonstrated that the model could accurately fit the experimental data and adequately reflect the effect of various factors on the EO yield. The primary term, secondary term, and interaction term all had a highly significant effect on the EO yield (p > 0.01), whereas AC and BC of the interaction term had no significant effect on the EO yield (p > 0.05). The factors affecting the yield of EO were ranked as follows: A (pectinase addition) > B (microwave power) > C (microwave time). The amount of pectinase added had the greatest effect on the yield of EO, followed by the microwave power and the microwave time. The verification test used 69.17 μmol of pectinase, 651.42 W of microwave power, and 43.84 min of optimal extraction time. On this basis, the obtained EO yield was 14.63 mL/kg DW.

Table 2.
Box-Behnken design (BBD) with experimental value for a total yield of EO (mL/kg DW), analysis of variance (ANOVA) for response surface quadratic model, and fit statistics for response values.
3.1.4. Validation Test
Within the test range for various factors, the optimal process parameters were determined with the yield of EO as the optimization objective. Add pectinase 69.17 μmol, microwave power 700 W, extraction time 44 min, three repeated experiments were conducted, and the average yield of EO was 14.41 mL/kg DW. These values did not differ significantly from the predicted ones and could be extracted further under the modified conditions [29].
3.2. EO Compounds
GC-MS analysis was used to determine the compounds of EOA (EO obtained by microwave-assisted distillation) and EOB (EO obtained by steam distillation). The findings in Table 3 showed that a total of 23 compounds were detected in the EO, the main compounds of PPEO were Limonene (79.31%), Myrcene (3.76%), and α-Phellandrene (4.72%) et al., which were the primary components of the pomelo peel EO, accounting for more than 85% of the total amount of the EO. Compared with traditional heating, microwave-assisted distillation using high-frequency electromagnetic waves makes the material within the molecule collide under the effect of an electric field, the electromagnetic energy enters as heat energy, thereby enhancing the penetration ability of microwave heating. The extraction efficiency of microwaves is higher than that of traditional methods [30,31].

Table 3.
Chemical constituents of essential oil from pomelo peel.
3.3. Bioactivity of Essential Oils
3.3.1. Pseudocercospora Isolation
The Pseudocercospora isolation material was obtained from rotten diseased guava epidermis (purchased from a farmer in Meizhou, Guangdong, China), and the rotten diseased parts were cut and isolated by the gradient dilution method, and then incubated at 26 °C for 48 h. Gram staining was used to identify the pseudocercospora isolation, and their appearance was observed using a 100× electron microscope. PF appears as filamentous tangles with no tissue growth. The pseudocercospora isolation i in the medium was dark brown heads, white caudal spores, and radially grew in culture. However, when the number of PF reaches a certain level, the white body completely covers the pseudocercospora isolation; the pseudocercospora isolation consumes the medium at a certain point during incubation, increasing the volume by tens or even hundreds of times.
3.3.2. Antifungal Process
Pseudocercospora isolation was grown in various concentrations of EO medium for a total of 120 h. As illustrated in Figure 4, the growth of different concentrations of EO medium is also indeterminate. In general, as the concentration of the EO in the medium per unit time increases, the growth area of pseudocercospora decreases, and the intensity of antifungal is proportional to the EO medium concentration [32,33].
Figure 4.
Antifungal process of PPEO.
The strain did not grow within the first 24 h, but diffusion growth of the pseudocercospora was observed after 48 h of incubation (EO concentration in the medium 0–3 mg/mL, 48 h). As the increase of culture time, the growth trend of PF was more obvious, and when the incubation time was increased to 120 h, pseudocercospora growth was widespread and regular in the concentration range of 0–3 mg/mL. The PF grew evenly around the circular filter paper sheet at a concentration of 3 mg/mL, with the black pseudocercospora head in the center and the white fluffy shape of the outer ring representing the tail spores, which are round and evenly distributed. When the culture time exceeds 72 h, the range of the pseudocercospora in the culture medium had little changed with different concentrations of essential oil, and the coverage rate of the negative control group with 0% EO content was all over 90%. When the EO concentration is up to 3.5 mg/mL, it always had a significant antifungal effect all the time, while the antifungal rate of the 3.5 mg/mL EO solution was 100%. With the decrease of the EO concentration, the antifungal rate was gradually reduced, the antifungal rate of 3 mg/mL EO solution was 66.67%, followed by the rate of 56.58% of 2.5 mg/mL and 47.5% of 0.5 mg/mL. The EO medium concentration was increased to 3.5 mg/mL to achieve the antifungal effect for 120 h, while the pseudocercospora remained non-viable. Thus, when the concentration of pomelo peel EO was greater than 3.5 mg/mL, it exhibited a significant antifungal property. Experiments have demonstrated that PPEO can be used as a natural, pollutant-free pesticide [34,35].
4. Conclusions
The raw material for pomelo peel was pretreated by the screw extrusion method, and several impact factors affecting the yield of PPEO were optimized and evaluated by a single-factor experiment combined with the response surface method. The optimal conditions were: 69.17 μmol/g pectinases were added, 651.42 W microwave power was used, and 43.84 min was the optimal extraction time. The highest yield of EO was 14.63 mL/kg DW. The compounds of Limonene were the highest (79.31%) in the EO, followed by α-Phellandrene (4.72%) and Myrcene (3.46%). Additionally, the pseudocercospora was isolated and cultured from diseased guava, and the morphology of the pseudocercospora was visualized by electron microscopy. The antifungal property was significantly effective when the PPEO concentration was increased to 3.5 mg/mL. These findings indicate that the PPEO has potential use in the future development of agricultural antibiotics.
Author Contributions
Conceptualization and writing, X.Z. and Y.H.; software, Y.H. and Y.N.; data analysis, M.C. and L.Z.; graphics rendering, Y.A.; validation, Z.L. All authors have read and agreed to the published version of the manuscript.
Funding
This research was funded by Meizhou Science and Technology Fund, grant number 2021B0204007, 2021B0204001, Key Scientific Research Platform Project of Guangdong Universities, grant number 2019GCZX007, Key Project of Rural Science and Technology Correspondent stationed in Village of Guangdong Province, grant number KTP20210213, Science and Technology program of Guangdong Province, grant number 2020B121201013, Science and Technology program of Guangdong Province, grant number 2020B0201001 and Meizhou Applied Science and Technology Special Fund Project, grant number 2020B0205004.
Data Availability Statement
The data shown in this study are contained within the article.
Conflicts of Interest
The authors declare no conflict of interest.
References
- Dehghani Bidgoli, R. Chemical Composition of Essential Oil and Antifungal Activity of Artemisia Persica boiss. from Iran. J. Food Sci. Technol. 2021, 58, 1313–1318. [Google Scholar] [CrossRef]
- Darmadi, A.A.K.; Sudirga, S.K.; Suriani, N.L.; Wahyuni, I.G.A.S. Antifungal Activities of Cinnamon Leaf Extracts against Sigatoka Fungus (Pseudocercospora fijiensis). IOP Conf. Ser. Earth Environ. Sci. 2019, 347, 012051. [Google Scholar] [CrossRef]
- Seshadri, V.D.; Balasubramanian, B.; Al-Dhabi, N.A.; Esmail, G.A.; Arasu, M.V. Essential Oils of Cinnamomum Loureirii and Evolvulus Alsinoides Protect Guava Fruits from Spoilage Bacteria, Fungi and Insect (Pseudococcus longispinus). Ind. Crops Prod. 2020, 154, 112629. [Google Scholar] [CrossRef]
- Chen, C.J.; Li, Q.Q.; Ma, Y.N.; Wang, W.; Cheng, Y.X.; Xu, F.R.; Dong, X. Antifungal Effect of Essential Oils from Five Kinds of Rutaceae Plants—Avoiding Pesticide Residue and Resistance. Chem. Biodivers. 2019, 16, e1800688. [Google Scholar] [CrossRef]
- Brauer, V.S.; Rezende, C.P.; Pessoni, A.M.; De Paula, R.G.; Rangappa, K.S.; Nayaka, S.C.; Gupta, V.K.; Almeida, F. Antifungal Agents in Agriculture: Friends and Foes of Public Health. Biomolecules 2019, 9, 521. [Google Scholar] [CrossRef] [Green Version]
- Nguyen, V.T. Sunlight-Driven Synthesis of Silver Nanoparticles Using Pomelo Peel Extract and Antibacterial Testing. J. Chem. 2020, 2020, 6407081. [Google Scholar] [CrossRef]
- Xiao, L.; Ye, F.; Zhou, Y.; Zhao, G. Utilization of Pomelo Peels to Manufacture Value-Added Products: A Review. Food Chem. 2021, 351, 129247. [Google Scholar] [CrossRef]
- Dao, T.P.; Phong, H.X.; Cang, M.H.; Bach, L.G.; Van Muoi, N. Kinetic Modeling of Essential Oil Hydro-Distillation from Peels of Pomelo (Citrus grandis L.) Fruit Grown in Southern Vietnam. Sains Malays. 2021, 50, 3251–3261. [Google Scholar]
- Tuan, N.T.; Dang, L.N.; Huong, B.T.C.; Danh, L.T. One Step Extraction of Essential Oils and Pectin from Pomelo (Citrus grandis) Peels. Chem. Eng. Process. Process Intensif. 2019, 142, 107550. [Google Scholar] [CrossRef]
- Peng, X.; Feng, C.; Wang, X.; Gu, H.; Li, J.; Zhang, X.; Zhang, X.; Yang, L. Chemical Composition and Antioxidant Activity of Essential Oils from Barks of Pinus Pumila Using Microwave-Assisted Hydrodistillation after Screw Extrusion Treatment. Ind. Crops Prod. 2021, 166, 113489. [Google Scholar] [CrossRef]
- Peng, X.; Yang, X.; Gu, H.; Yang, L.; Gao, H. Essential Oil Extraction from Fresh Needles of Pinus Pumila (Pall.) Regel Using a Solvent-Free Microwave-Assisted Methodology and an Evaluation of Acetylcholinesterase Inhibition Activity in Vitro Compared to That of Its Main Components. Ind. Crops Prod. 2021, 167, 113549. [Google Scholar] [CrossRef]
- Megawati; Fardhyanti, D.S.; Sediawan, W.B.; Hisyam, A. Kinetics of Mace (Myristicae arillus) Essential Oil Extraction Using Microwave Assisted Hydrodistillation: Effect of Microwave Power. Ind. Crops Prod. 2019, 131, 315–322. [Google Scholar]
- Valderrama, F.; Ruiz, F. An Optimal Control Approach to Steam Distillation of Essential Oils from Aromatic Plants. Comput. Chem. Eng. 2018, 117, 25–31. [Google Scholar] [CrossRef]
- Kawai, H.; Kuraya, E.; Touyama, A.; Higa, O.; Hokamoto, K.; Tokeshi, K.; Yasuda, A.; Naragaki, T.; Itoh, S. Improved Yield and Antioxidant Activity of Essential Oil from Alpinia Zerumbet (Zingiberaceae) Leaves by Underwater Shockwave Pretreatment. Food Bioprod. Process. 2021, 125, 134–140. [Google Scholar] [CrossRef]
- Zhao, S.; Baik, O.D. Application of Ultrasound as Pretreatment for Extraction of Podophyllotoxin from Rhizomes of Podophyllum Peltatum. Ultrason. Sonochem. 2012, 19, 22–31. [Google Scholar] [CrossRef]
- Trujillo-Juárez, L.G.; Hernández-Meléndez, Ó.; Gimeno, M.; Gracia-Fadrique, J.; Bárzana, E. Extraction of Essential Oil from Waste Grapefruit Peel Using a Pilot-Scale Twin-Screw Extruder. ACS Food Sci. Technol. 2021, 1, 1198–1205. [Google Scholar] [CrossRef]
- Li, Q.; Zhou, Z.; Zhang, D.; Wang, Z.; Cong, W. Lipid Extraction from Nannochloropsis Oceanica Biomass after Extrusion Pretreatment with Twin-Screw Extruder: Optimization of Processing Parameters and Comparison of Lipid Quality. Bioprocess Biosyst. Eng. 2020, 43, 655–662. [Google Scholar] [CrossRef]
- Uitterhaegen, E.; Nguyen, Q.H.; Sampaio, K.A.; Stevens, C.V.; Merah, O.; Talou, T.; Rigal, L.; Evon, P. Extraction of Coriander Oil Using Twin-Screw Extrusion: Feasibility Study and Potential Press Cake Applications. JAOCS J. Am. Oil Chem. Soc. 2015, 92, 1219–1233. [Google Scholar] [CrossRef] [Green Version]
- Ming, Z.Q.; Liu, Y.Q.; Ye, Y.Y.; Li, S.R.; Zhao, Y.R.; Wang, D. Study of a New Combined Method for Pre-Extraction of Essential Oils and Catalytic Fast Pyrolysis of Pine Sawdust. Energy 2016, 116, 558–566. [Google Scholar] [CrossRef]
- Li, Z.; Wang, H.; Pan, X.; Guo, Y.; Gao, W.; Wang, J.; Dong, B.; Duan, M.; Yin, H.; Zhang, Q. Enzyme-Deep Eutectic Solvent Pre-Treatment for Extraction of Essential Oil from Mentha Haplocalyx Briq. Leaves: Kinetic, Chemical Composition and Inhibitory Enzyme Activity. Ind. Crops Prod. 2022, 177, 114429. [Google Scholar] [CrossRef]
- Marjamaa, K.; Kruus, K. Enzyme Biotechnology in Degradation and Modification of Plant Cell Wall Polymers. Physiol. Plant. 2018, 164, 106–118. [Google Scholar] [CrossRef] [PubMed]
- Feng, Y.N.; Zhang, X.F. Polysaccharide extracted from Huperzia serrata using response surface methodology and its biological activity. Int. J. Biol. Macromol. 2020, 157, 267–275. [Google Scholar] [CrossRef] [PubMed]
- Hu, B.; Li, Y.; Song, J.; Li, H.; Zhou, Q.; Li, C.; Zhang, Z.; Liu, Y.; Liu, A.; Zhang, Q. Oil extraction from tiger nut (Cyperus esculentus L.) using the combination of microwave-ultrasonic assisted aqueous enzymatic method—Design, optimization and quality evaluation. J. Chromatogr. A 2020, 1627, 461380. [Google Scholar] [CrossRef]
- Jiao, Z.; Zhang, Y.; Fan, H. Ultrasonic-microwave method in preparation of polypyrrole-coated magnetic particles for vitamin D extraction in milk. J. Chromatogr. A 2016, 1457, 7–13. [Google Scholar] [CrossRef] [PubMed]
- Sagarika, N.; Prince, M.V.; Kothakota, A.; Pandiselvam, R.; Sreeja, R.; Mathew, S.M. Characterization and Optimization of Microwave Assisted Process for Extraction of Nutmeg (Myristica fragrans Houtt.) Mace Essential Oil. J. Essent. Oil Bear. Plants 2018, 21, 895–904. [Google Scholar] [CrossRef]
- Zhang, H.; Cai, X.T.; Tian, Q.H.; Xiao, L.X.; Zeng, Z.; Cai, X.; Yan, J.; Li, Q.Y. Microwave-Assisted Degradation of Polysaccharide from Polygonatum sibiricum and Antioxidant Activity. J. Food Sci. 2019, 84, 754–761. [Google Scholar] [CrossRef]
- Jeyaratnam, N.; Nour, A.H.; Kanthasamy, R.; Nour, A.H.; Yuvaraj, A.R.; Akindoyo, J.O. Essential Oil from Cinnamomum Cassia Bark through Hydrodistillation and Advanced Microwave Assisted Hydrodistillation. Ind. Crops Prod. 2016, 92, 57–66. [Google Scholar] [CrossRef] [Green Version]
- Srinivas, Y.; Mathew, S.M.; Kothakota, A.; Sagarika, N.; Pandiselvam, R. Microwave Assisted Fluidized Bed Drying of Nutmeg Mace for Essential Oil Enriched Extracts: An Assessment of Drying Kinetics, Process Optimization and Quality. Innov. Food Sci. Emerg. Technol. 2020, 66, 102541. [Google Scholar] [CrossRef]
- Nagendra Chari, K.L.; Manasa, D.; Srinivas, P.; Sowbhagya, H.B. Enzyme-Assisted Extraction of Bioactive Compounds from Ginger (Zingiber officinale Roscoe). Food Chem. 2013, 139, 509–514. [Google Scholar] [CrossRef]
- Chen, Q.; Hu, Z.; Yao, F.Y.D.; Liang, H. Study of Two-Stage Microwave Extraction of Essential Oil and Pectin from Pomelo Peels. LWT 2016, 66, 538–545. [Google Scholar] [CrossRef]
- Liu, Z.; Li, H.; Zhu, Z.; Huang, D.; Qi, Y.; Ma, C.; Zou, Z.; Ni, H. Cinnamomum Camphora Fruit Peel as a Source of Essential Oil Extracted Using the Solvent-Free Microwave-Assisted Method Compared with Conventional Hydrodistillation. LWT 2022, 153, 112549. [Google Scholar] [CrossRef]
- Rguez, S.; Djébali, N.; Ben Slimene, I.; Abid, G.; Hammemi, M.; Chenenaoui, S.; Bachkouel, S.; Daami-Remadi, M.; Ksouri, R.; Hamrouni-Sellami, I. Cupressus Sempervirens Essential Oils and Their Major Compounds Successfully Control Postharvest Grey Mould Disease of Tomato. Ind. Crops Prod. 2018, 123, 135–141. [Google Scholar] [CrossRef]
- Xie, Y.; Wang, Z.; Huang, Q.; Zhang, D. Antifungal Activity of Several Essential Oils and Major Components against Wood-Rot Fungi. Ind. Crops Prod. 2017, 108, 278–285. [Google Scholar] [CrossRef]
- Uysal, B.; Sozmen, F.; Aktas, O.; Oksal, B.S.; Kose, E.O. Essential Oil Composition and Antibacterial Activity of the Grapefruit (Citrus paradisi. L.) Peel Essential Oils Obtained by Solvent-Free Microwave Extraction: Comparison with Hydrodistillation. Int. J. Food Sci. Technol. 2011, 46, 1455–1461. [Google Scholar] [CrossRef]
- Viuda-Martos, M.; Ruiz-Navajas, Y.; Fernández-López, J.; Pérez-Álvarez, J. Antifungal Activity of Lemon (Citrus lemon L.), Mandarin (Citrus reticulata L.), Grapefruit (Citrus paradisi L.) and Orange (Citrus sinensis L.) Essential Oils. Food Control 2008, 19, 1130–1138. [Google Scholar] [CrossRef]
Publisher’s Note: MDPI stays neutral with regard to jurisdictional claims in published maps and institutional affiliations. |
© 2022 by the authors. Licensee MDPI, Basel, Switzerland. This article is an open access article distributed under the terms and conditions of the Creative Commons Attribution (CC BY) license (https://creativecommons.org/licenses/by/4.0/).





